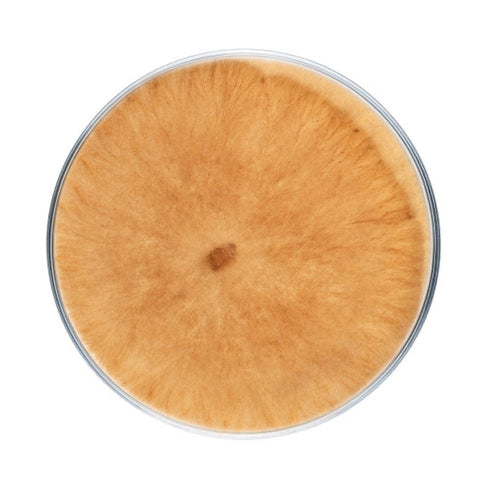

Morel Mushroom Plate Culture

Species difficulty | Experimental |
Culture format | Agar plate |
Lab skills | Intermediate |
Shelf life | 6 months (refrigerated) |
Plate cultures are ideal for growers looking to make master bags, inoculate grain, make liquid culture, or make more plates.
Our morel plates are made to order in our in-house lab using medical-grade petri dishes. If properly stored upon arrival, they have a shelf life of approximately 6 months. Morel plates should be stored in the refrigerator to maintain viability. Note that mycelium cultures require basic lab skills. Handle using sterile technique to prevent contamination.
For complete descriptions of available morel strains, click on the names below.
-
Morchella esculenta. Morel strain from a culture collection in New York.
-
Morchella esculentoides. Spore isolate from a morel from the mid-western US.
-
Morchella exuberans. Cloned from a wild specimen in NH found growing under fruit trees.
-
Morchella spp. Found poking out of the sidewalk just a few steps from our Westbrook, Maine facility (thus the name "Brown Street Baby" morel).